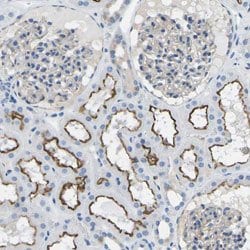
MC4R, Rabbit anti-Human, Polyclonal Antibody, Abnova 100&mu;L; Unconjugated:Antibodies,

missing translation for 'onlineSavingsMsg'
Learn More
Learn More
MC4R, Rabbit anti-Human, Polyclonal Antibody, Abnova™
Rabbit Polyclonal Antibody
Brand: Abnova PAB30883.100uL
This item is not returnable.
View return policy
Description
Sequence: MVNSTHRGMHTSLHLWNRSSYRLHSNASESLGKGYSDGGCYEQLSpecifications
| MC4R | |
| Polyclonal | |
| Immunohistochemistry (Formalin/PFA-fixed paraffin-embedded sections) (1:20-1:50) The optimal working dilution should be determined by the end user. | |
| melanocortin 4 receptor | |
| MC4R | |
| Recombinant protein corresponding to human MC4R. | |
| RUO | |
| 4160 | |
| Store at 4°C. For long term storage store at -20°C. Aliquot to avoid repeated freezing and thawing. | |
| Liquid |
| Immunohistochemistry (Paraffin) | |
| Unconjugated | |
| In PBS, pH 7.2 (40% glycerol, 0.02% sodium azide). | |
| MGC126851/MGC138197 | |
| Rabbit | |
| 100 μL | |
| Primary | |
| Human | |
| Antibody | |
| IgG |
Product Content Correction
Your input is important to us. Please complete this form to provide feedback related to the content on this product.
Product Title
Spot an opportunity for improvement?Share a Content Correction